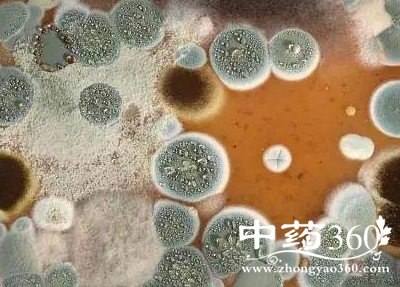

毛孢子菌病有哪些症状 毛孢子菌病的治疗偏方
毛孢子菌病是由于毛孢子菌引发的皮肤性疾病吗,它主要是发生在年轻男性的生殖器周围,所以患者在生活中出现了这种疾病,可以采用一些四君汤或者其他的药材是治疗它,因为这些药材可以很好的抑制毛孢子菌的生长和繁殖,所以对于治疗毛孢子菌病是有很好的疗效的,希望患者可以采用。
偏方一
材料:丹皮15 g,淮牛膝15 g,木瓜10 g,薏苡仁15 g,秦艽10 g,赤芍12 g,夏枯草15 g,皂角刺10 g,紫花地丁20 g)。
用法:水煎服,1 剂/d,分3 次服,守方10余剂。
偏方二
材料:选用四君子汤(泡参、白术、茯苓、甘草)或参苓白术散(泡参、白术、茯苓、薏苡仁、桔梗、莲肉、山药、甘草)合二至丸(女贞子、旱莲草)等方药进行加减。
偏方三
用法:5%~10%碘化钾3g/d,可渐增加到6~8g/d,损害消失可继服2~4周,一般疗程2~3个月。碘化钾饱和液10滴/次,3次/d,可渐增加到40滴,3次/d,一般1周见效,1~2个月可治愈。
注意事项:口服碘化钾有消化不良或恶心、呕吐、胃纳不佳等胃肠道反应时,可用碘化钠1g/d静脉推注。如患者有肺结核,碘化钾不宜应用。
毛孢子菌病的发生主要是患者平时没有多去注重生殖器周围的清洗造成的细菌滋生情况,对于这种疾病的治疗,首先还是患者要在生活中多注意去清洗生殖器周围的皮肤和坚持使用文章介绍的治疗偏方,才能够在生活中更好的杀死毛孢子菌。
热点排行
-
分享牛大力壮阳偏方 牛大力壮阳偏方 牛大力壮阳偏方有很多,最有效最简单的方法就是把它和生蚝放在一起煲汤喝, … [详情] -
芎芷石膏汤歌诀 头痛眩晕可服用芎芷石膏汤 处方芎芷石膏汤系由川芎、白芷、石膏、菊花、羌活、藁本组成,具有散风泄热 … [详情] -
逍遥散的组成 逍遥散的功效作用 由逍遥散化裁出了许多方剂,广泛运用于临床各科,多以柴胡、当归、白芍、甘 … [详情] -
温胆汤不适合哪些人喝 温胆汤有什么副作用 说起中药方剂,大家在日常生活中时常都碰见或者听闻某某配方能够治疗什么疾 … [详情] -
乌头汤方解 乌头汤组成 乌头汤方歌 寒湿痹证乌头汤,黄芪草芍配麻黄,说的就是乌头汤方歌!乌头汤处方是什么, … [详情]
好文阅读
-
儿童饮食如何选择 怎样饮食更健康 目前有许多厂家和商家有意将保健食品误导为药品,即使是健康无病者也都希望 … [详情] -
阴囊疾病的解决方法 阴囊疾病的症状 多由于忧愁、发怒等长期精神刺激,以及失眠等原因,而引起阴囊皮肤的剧烈瘙 … [详情] -
吃苹果千万别吃核 你知道原因吗 但也不必过分担心,苹果中的氢氰酸主要存在于果核,果肉里并没有。需要提醒 … [详情] -
中暑高危群的7类人这个夏天要当心了 【导读】中暑高危群的7类人这个夏天要当心了!夏天到了,天气也在一天天的 … [详情] -
经常吃土豆延缓衰老 益寿延年 土豆又叫马铃薯,含有丰富的淀粉还有各种微量元素,常吃土豆能够延缓衰老, … [详情]

















